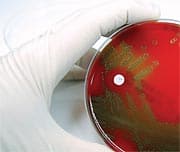
Branched Chain Amino Acids and Calorie Restriction

Life Extension Magazine®
For years, fitness enthusiasts have used branched chain amino acids to boost muscle strength and performance.1-3 New research shows why longevity enthusiasts may also incorporate them into their nutritional regimen. A study recently published in the respected clinical journal Cell Metabolism4 reveals that branched chain amino acids (BCAAs) have the power to increase life span in part by inducing mitochondrial biogenesis—the spontaneous generation of new mitochondria. In this article, the results of this study are detailed. BCAAs may complement the life span effects of both pyrroloquinoline quinone (PQQ) and resveratrol.5-7 Specifically, BCAAs may trigger cellular mechanisms that enhance mitochondrial number and function while also upregulating expression of the pro-longevity gene that resveratrol targets: sirtuin-1!1,6,7 The Building Blocks of Life and LongevityAs the foundation of life and the engines that drive cellular metabolism, amino acids are the building blocks for all proteins.
The three essential branched chain amino acids are leucine, isoleucine, and valine. In concert with other simple amino acids, BCAAs comprise the functional proteins that form the structural basis of human physiology, from skeletal and cardiac musculature to the vast universe of life-sustaining enzymes. In humans, whose total muscle mass accounts for about 40% of body weight, BCAAs make up nearly a fifth of all muscle proteins.1 In the landmark Cell Metabolism study, a team of scientists went beyond BCAAs’ metabolic effects to explore their potential to boost life span.4 This effort was based on prior studies indicating that the BCAAs leucine, isoleucine, and valine prolonged life in the yeast species Saccharomyces cerevisiae.8 Lead researcher Giuseppe D’Antona and his team fed male mice a diet that included BCAA-enriched drinking water.4 Mice ingesting BCAAs experienced a 12% increase in median life span from 774 days for untreated controls to 869 days in the treatment group. Because there was no significant difference in food intake, body weight, and body fat content between the treated and untreated animals, the authors concluded that the increased life span seen in the BCAA-enriched cohort was not a function of decreased body fat but rather the BCAAs themselves. It was further discovered that mice enjoying increased longevity had high levels of SIRT1,4 a mammalian form of sirtuins, a subset of genes conclusively linked to increased longevity across a range of species.6,7,9 BCAA-treated mice also exhibited upregulation of genetic defense systems that blunt the detrimental effects of specific reactive oxygen species (ROS)4 associated with cellular and somatic (body) aging in many organisms, including mammals. BCAA-fed groups further experienced a dose-dependent response of new mitochondrial formation4 or mitochondrial biogenesis, as measured through specific markers of cellular energetic output in heart muscle cells.
Exercise was shown to further enhance the mitochondrial function induced by BCAAs.4 Trained, BCAA-fed mice exhibited greater amounts of mitochondria in heart and skeletal muscle when those tissues were examined by electron microscopy. The BCAAs treatment groups also showed greater endurance scores on treadmill tests and better performance in tests of motor coordination, seen to an even greater degree in exercise-trained animals.1 Dr. D’Antona’s study included a second group of mice that carry a specific mutation. These mutant mice lack a key enzyme involved in blood vessel relaxation and regulation called endothelial nitric oxide synthase or eNOS.4 Without eNOS, mice die earlier and develop cardiovascular disease and other age-related pathologies similar to humans suffering from metabolic syndrome.10 Mice lacking the eNOS enzyme did not experience the same benefits of longer life span, improved ability to form new mitochondria, increased expression of SIRT1, or enhanced defense against ROS in response to BCAAs treatment.4 This led the researchers to conclude that healthy eNOS activity also plays a key role in BCAAs’ pro-longevity action, mitochondrial biogenesis, and reduced oxidative stress.4 Unique, Systemic BenefitsOnce ingested, dietary BCAAs are transported and metabolized by a group of specific enzymes. What makes BCAAs unique among amino acids is that they are not broken down in the liver. Instead, they enter the bloodstream and are directly absorbed into the skeletal muscle.11 There they enter the cellular powerhouses known as mitochondria, the source of over 90% of all energetic output in the human body.1 Exercise was shown to further enhance the mitochondrial function induced by BCAAs.
BCAAs exert a profound influence over metabolic processes central to protein synthesis. Leucine also appears to play a particularly key role in protein formation and the regulation of protein metabolism.12 Human studies that have examined these exceptional actions in the bloodstream and skeletal muscle point to a role for BCAAs in muscle recovery from fatigue or intensive physical activity such as strength training.1,2 A 2010 review published in the Journal of the International Society of Sports Nutrition cited the power of BCAAs to bolster muscle protein building and delay the onset of fatigue as key benefits for exercising individuals.3 The paper also noted the possible effectiveness of BCAAs as performance enhancers. In addition to their newly confirmed pro-longevity and mitochondria-generating effects, BCAAs show promise in fighting multiple killer diseases of aging.
Human trials reveal favorable effects of essential amino acid ingestion, including BCAAs, on insulin sensitivity and blood glucose control, as demonstrated in a study of 34 elderly diabetic subjects over a test period of more than a year. A BCAA-rich amino acid mixture improved numerous parameters of blood sugar metabolism, including hemoglobin A1c, in this group of older adults with poorly controlled diabetes.13
BCAA-enriched amino acid mixtures have also shown promise for improving the muscle-wasting condition known as sarcopenia in elderly human subjects, who gained muscle mass during treatment.14 This finding holds important implications for BCAAs’ use in other conditions characterized by debilitation and muscle loss. Since BCAAs are involved in the formation and maintenance of glutamate and the neurotransmitter gamma-aminobutyric acid (GABA) in brain tissue, researchers believe they may play a role in supporting healthy nervous system function. Studies in animal models have shown promise that oral BCAA administration can improve the devastating consequences of traumatic brain injury by improving cognitive performance.15
SummaryThe branched chain amino acids leucine, isoleucine, and valine are essential to human nutrition. While BCAAs have been successfully studied and applied in optimizing muscle development and athletic performance, a new study reveals they can extend life and combat age-promoting cellular injury, perhaps through BCAAs’ abilities to foster mitochondrial proliferation. If you have any questions on the scientific content of this article, please call a Life Extension® Wellness Specialist at 1-866-864-3027.
Editor's NoteScience continues to evolve, and new research is published daily. As such, we have a more recent article on this topic: How Whey Protein Fights Aging |
| References |
1. Harper AE, Miller RH, Block KP. Branched chain amino acid metabolism. Annu Rev Nutr. 1984; 4:409-54. 2. Sharp CP, Pearson DR. Amino acid supplements and recovery from high-intensity resistance training. J Strength Cond Res. 2010 Apr;24(4):1125-30. 3. Kreider RB et al. ISSN exercise & sport nutrition review: research & recommendations. J Int Soc Sports Nutr. 2010 Feb 2;7:7. 4. D’Antona G, Ragni M, Cardile A, et al. Branched chain amino acid supplementation promotes survival and supports cardiac and skeletal muscle mitochondrial biogenesis in middle-aged mice. Cell Metab. 2010 Oct 6;12(4):362-72. 5. Chowanadisai W, Bauerly KA, Tchaparian E, Wong A, Cortopassi GA, Rucker RB. Pyrroloquinoline quinone stimulates mitochondrial biogenesis through cAMP response element-binding protein phosphorylation and increased PGC-1alpha expression. J Biol Chem. 2010 Jan 1;285(1):142-52. 6. Kelly G. A review of the sirtuin system, its clinical implications, and the potential role of dietary activators like resveratrol: part 1. Altern Med Rev. 2010 Sep;15(3):245-63. 7. Kelly GS. A review of the sirtuin system, its clinical implications, and the potential role of dietary activators like resveratrol: part 2. Altern Med Rev. 2010 Dec;15(4):313-28. 8. Alvers AL, Fishwick LK, Wood MS, Hu D, Chung HS, Dunn WA Jr, Aris JP. Autophagy and amino acid homeostasis are required for chronological longevity in Saccharomyces cerevisiae. Aging Cell. 2009 Aug;8(4):353-69. 9. Canto C, Auwerx J. Caloric restriction, SIRT1 and longevity. Trends Endocrinol Metab. 2009 Sep;20(7):325-31. 10. Cook S, Hugli O, Egli M, et al. Clustering of cardiovascular risk factors mimicking the human metabolic syndrome X in eNOS null mice. Swiss Med Wkly. 2003 Jun 28;133(25-26):360-3. 11. Shimomura Y, Yamamoto Y, Bajotto G, et al. Nutraceutical effects of branched chain amino acids on skeletal muscle. J Nutr. 2006 Feb;136(2):529S-532S. 12. Mero A. Leucine supplementation and intensive training. Sports Med. 1999 Jun;27(6):347-58. 13. Solerte SB, Fioravanti M, Locatelli E, et al. Improvement of blood glucose control and insulin sensitivity during a long-term (60 weeks) randomized study with amino acid dietary supplements in elderly subjects with type 2 diabetes mellitus. Am J Cardiol. 2008 Jun 2;101(11A):82E-88E. 14. Solerte SB, Gazzaruso C, Bonacasa R, et al. Nutritional supplements with oral amino acid mixtures increases whole-body lean mass and insulin sensitivity in elderly subjects with sarcopenia. Am J Cardiol. 2008 Jun 2;101(11A):69E-77E. 15. Cole JT, Mitala CM, Kundu S, Verma A, Elkind JA, Nissim I, Cohen AS. Dietary branched chain amino acids ameliorate injury-induced cognitive impairment. Proc Natl Acad Sci U S A. 2010 Jan 5;107(1):366-71. 16. Potier M, Darcel N, Tome D. Protein, amino acids and the control of food intake. Curr Opin Clin Nutr Metab Care. 2009 Jan;12(1):54-8. 17. Woods SC, Seeley RJ, Cota D. Regulation of food intake through hypothalamic signaling networks involving mTOR. Annu Rev Nutr. 2008;28:295-311. 18. Cota D, Proulx K, Smith KA, Kozma SC, Thomas G, Woods SC, Seeley RJ. Hypothalamic mTOR signaling regulates food intake. Science. 2006 May 12;312(5775):927-30. 19. Cota D. Mammalian target of rapamycin complex 1 (mTORC1) signaling in energy balance and obesity. Physiol Behav. 2009 Jul 14;97(5):520-4. 20. Zhang YJ, Duan Y, Zheng XF. Targeting the mTOR kinase domain: the second generation of mTOR inhibitors. Drug Discov Today. 2011 Feb 16. 21. Available at: www.clinicaltrials.gov. Accessed February 26, 2011. 22. Qin LQ, Xun P, Bujnowski D, et al. Higher branched chain amino acid intake is associated with a lower prevalence of being overweight or obese in middle-aged East Asian and Western adults. J Nutr. 2011 Feb;141(2):249-54. 23. Jitomir J, Willoughby DS. Leucine for retention of lean mass on a hypocaloric diet. J Med Food. 2008 Dec;11(4):606-9. 24. Devkota S, Layman DK. Protein metabolic roles in treatment of obesity. Curr Opin Clin Nutr Metab Care. 2010 Jul;13(4):403-7. 25. Layman DK, Walker DA. Potential importance of leucine in treatment of obesity and the metabolic syndrome. J Nutr. 2006 Jan;136(1 Suppl):319S-23S. 26. Moriwaki H, Shiraki M, Fukushima H, et al. Long-term outcome of branched chain amino acid treatment in patients with liver cirrhosis. Hepatol Res. 2008 Nov;38(s1The 6 Japan Society of Hepatology Single Topic Conference: Liver Failure: Recent Progress and Pathogenesis to Management. 28-29 September 2007, Iwate, Japan):S102-S106. 27. Kawaguchi T, Nagao Y, Matsuoka H, Ide T, Sata M. Branched chain amino acid-enriched supplementation improves insulin resistance in patients with chronic liver disease. Int J Mol Med. 2008 Jul;22(1):105-12. 28. van Norren K, Kegler D, Argilés JM, et al. Dietary supplementation with a specific combination of high protein, leucine, and fish oil improves muscle function and daily activity in tumour-bearing cachectic mice. Br J Cancer. 2009 Mar 10;100(5):713-22. 29. Sax HC, Talamini MA, Fischer JE. Clinical use of branched chain amino acids in liver disease, sepsis, trauma, and burns. Arch Surg. 1986 Mar;121(3):358-66. 30. Shimomura Y, Inaguma A, Watanabe S, et al. Branched chain amino acid supplementation before squat exercise and delayed-onset muscle soreness. Int J Sport Nutr Exerc Metab. 2010 Jun;20(3):236-44. 31. Matsumoto K, Koba T, Hamada K, Sakurai M, Higuchi T, Miyata H. Branched chain amino acid supplementation attenuates muscle soreness, muscle damage and inflammation during an intensive training program. J Sports Med Phys Fitness. 2009 Dec;49(4):424-31. |